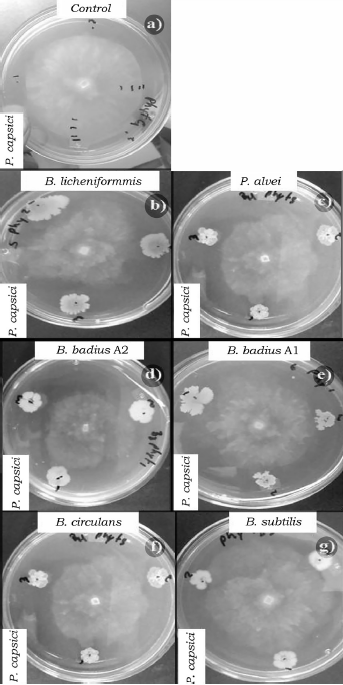

Introducción
El composteo se ha convertido en una herramienta para disponer de los desechos orgánicos, que al incluir lombrices al proceso ha llevado a una mejor calidad. Se ha reportado que las lombrices aplicadas en el lombricomposteo benefician la estructura microbiana al pasar a través de su tracto digestivo además de que almacenan algunos metales pesados (Hong, Wook, Su, Sam & Sub, 2011), lo cual produce un humus y lixiviado rico en nutrientes como fósforo, potasio y con compuestos que funcionan en la disminución de diversas enfermedades en plantas (Scheuerell & Mahaffee, 2002). Estas enfermedades son producidas principalmente por hongos, bacterias, nematodos y virus fitopatógenos, de los cuales los hongos son el grupo de mayor relevancia económica, debido a que se conocen más de 8000 especies de hongos que producen enfermedades en las plantas (Juárez-Becerra, Sosa-Morales & López-Malo, 2010), en comparación de las 50 que producen enfermedades en el hombre o en los animales (Guarro, 2012).
Con fines de controlarlos, se han desarrollado diversos productos químicos que terminan depositados en los suelos, afectando aguas colindantes y la atmósfera, generando un gran impacto ambiental (Ramírez & Lacasaña, 2001), en particular por la capacidad de adaptación de los fitopatógenos a estos compuesto. Se han reportado que especies de Phytophthora sp. (SilvaRojas, Fernandez-Pavía, Góngora-Canul, Macías-Lopéz & Ávila-Quezada, 2009), Fusarium sp. (González-Pérez, Yañe-Morales, Ortega-Escobar & Velázquez-Mendoa, 2009) y Alternaria sp. (Chaerani & Voorrips, 2006) presentan una alta variabilidad genética, que los beneficia al generar resistencia a diversos compuestos químicos que se aplican al campo. Sin embargo, actualmente se han desarrollado nuevas tecnologías para el control de hongos fitopatógenos basándose en compuestos u organismos que de forma natural presenten un efecto biocontrol sobre estos organismos y sean amigables con el medio ambiente. Se ha descrito la reducción de enfermedades causadas por hongos fitopatógenos al aplicar lixiviado de lombricomposta a cultivos agrícolas; sin embargo, no se ha descrito la procedencia de los compuestos que realizan este efecto inhibidor (Scheuerell & Mahaffee, 2002), además la realización de lombricompostaje debe de ser precisa ya que en sus fases de pre-composteo y maduración del lombricompostaje puede generar organismos que afecten tanto el desarrollo de la lombriz, así como un buen producto que funcione como bio-fertilizante. Dentro de los lixiviados de lombricomposta se ha descubierto la presencia de bacterias del orden Bacillales, a las cuales se les ha reconocido como productoras de antibióticos, enzimas líticas, con capacidad de solubilización de fosfatos y de fijación biológica de nitrógeno (Chen et al., 2006; Ooi, Ariff, Halimi & Shamsuddin, 2008; TejeraHernández, Rojas-Badia & Heydrich-Pérez, 2011). Además se han caracterizado como bacterias promotoras de crecimiento vegetal debido a la secreción de ácido índole-3-acético giberelinas y citoquininas, que son hormonas que promueven el crecimiento y desarrollo de organismos vegetales (Beneduzi, Ambrosini & Passaglia, 2012; Bloemberg & Lugtenberg, 2001; Bottini, Cassan & Piccoli, 2004) y las cuales les dan características sobresalientes para ser utilizadas como sustituyentes de fitoquímicos y realizar un efecto bicontrol. Bacillus subtilis se ha descrito con capacidad antagónica contra Sclerotium cepivorum, Penicillum sp. (Astorgaquirós, Meneses-Montero, Zuñiga-Vega, Brenes-Madriz & Rivera-Mendez, 2013), Fusarium oxysporum, S. rolfsii y Rhizoctonia solani (Paredes-Escalante et al., 2009).
Esta especie previamente secreta quitinasas, que son proteínas encargadas de la degradación de la quitina que forma la pared celular de hongos (Tjalsma et al., 2004). En menor medida se ha descrito la misma capacidad en cepas como B. japonicum (Mojica-Marín et al., 2009), B. megaterium (Akgül & Mirik, 2008), B. licheniformis (Reinoso, Vaillant, Casadesus, Garcia & Alvarez-Rivera, 2007) y B. amyloliquefaciens (Sato, Fukuda & Morita, 2011). Las características que presentan las cepas del orden Bacillales las convierten en cepas con potencial como biocontroladoras de hongos fitopatógenos. Por tanto, en el presente estudio se realizó el aislamiento de cepas del orden Bacillales a partir de lixiviados de lombricomposta y se evaluó su capacidad antagónica frente a las cepas de P. capsici, F. oxysporum, A. solani y Rhizopus sp. con pruebas in vitro.
Materiales y métodos
Aislamiento e identificación de cepas del orden Bacillales
A partir de una muestra de 500 mL de lixiviado de lombricomposta obtenida en el Invernadero del Instituto de Ciencias Biomédicas (ICB) de la Universidad Autónoma de Ciudad Juárez (UACJ) se extrajo 1 mL de muestra para obtener una dilución 1:10 con agua destilada como diluyente y se colocó a baño maría a 80 °C durante 15 min, esto con la finalidad de obtener organismos formadores de esporas. Posteriormente, se inoculó 1 µL de esta dilución de lixiviado en una caja Petri con agar nutritivo y se dejó incubar en una cámara de crecimiento (Sheldon Manufacturing, INC modelo: GI2) a 37 °C ± 1 °C por 48 h. Todas las colonias se caracterizaron morfológica y bioquímicamente según las pruebas descritas en el manual de Bergey's (Holt & Krieg, 1994). Con la finalidad de corroborar la identificación de efectiva de las bacterias aisladas, se usó una cepa de B. subtilis “tipo” proporcionada del cepario del laboratorio de Microbiología de ICB. Para la identificación de las cepas del género Bacillus se emplearon cultivos bacterianos crecidos en agar y caldo nutritivo por 48 h. Todas las cepas se sometieron a tinciones de Gram y Fulton-Schaeffer para determinar el diámetro del bacilo y tipo de espora; prueba de la catalasa (Becton-Dickinson); amilasa (JALMEK); hidrólisis de gelatina; ureasa; reducción de nitrato a nitrito (Becton-DickinsonA), NaCl al 6.5%, pH ácido y alcalino, Voges-Proskauer-Rojo de metilo (MCD_LAB y B.D.); citrato de Simmons; producción de ácidos a partir de glucosa (Becton-Dickinson); xilosa (GOLDEN BELL), manitol y arabinosa (JALMEK) y crecimiento en anaerobiosis (ANA-PAK-SISTEMS).
Origen y mantenimiento de las cepas de hongos
Se realizó un muestreo en la central de abastos ubicada en Ciudad Juárez, Chihuahua, recolectando frutos con incidencia de hongos del género F. oxysporum y Rhizopus sp., así como un muestreo de hojas con incidencia de hongos del género A. solani en una nogalera ubicada en Ciudad Juárez, Chihuahua, las cuales fueron transportadas al laboratorio en bolsas de plástico. Las muestras fueron procesadas y almacenadas según la metodología de Valero, González & González, (2014). La identificación de los hongos se realizó siguiendo las claves de Barnett & Hunter (1998). La cepa de P. capsici fue proporcionada por el cepario del laboratorio de Genética Aplicada de ICB.
Estandarización de inóculos de bacterias y hongos
Las cepas bacterianas se inocularon en 10 mL de medio nutritivo líquido incubando a 37 °C ± 1 °C por 48 h. Se realizaron tres diluciones seriadas 1:10 con agua destilada colocando 5 µL de cada dilución en agar nutritivo e incubando a 37 °C ± 1 °C por 24 h, posteriormente se contabilizaron las unidades formadoras de colonias (UFC). Este procedimiento se realizó por triplicado con cada una de las cepas de Bacillus. Con respecto a las cepas de hongos, se inoculó 1 cm3 de agar con micelio en una caja de agar nutritivo y se midió el crecimiento radial de la colonia cada 24 h por 7 días, realizando el procedimiento con cada una de las cepas de A. solani, Rhizopus sp., F. oxysporum y P. capsici.
Competencia antagónica de las cepas del orden Bacillales
El experimento se realizó bajo un diseño completamente al azar. Para la realización de la competencia se basó en la metodología propuesta por Wang, Wang, Jin & Zheng (2013) con ciertas modificaciones. Se inoculó 1 cm3 de agar con micelio de la cepa de hongo en cajas Petri con agar nutritivo y se dejaron incubar a 28 °C ± 1 °C por 72 h para A. solani, 48 h para P. capsici y F. oxysporum y 24 h para Rhizopus sp. en una cámara de crecimiento. Al mismo tiempo se inoculó la cepa bacteriana en 10 mL de medio nutritivo líquido y se dejó incubar en una cámara de crecimiento a 37 °C ± 1 °C. Al finalizar el periodo de incubación en la caja Petri se midieron tres puntos a 15 mm desde la orilla del halo de crecimiento micelial del hongo y se colocaron 5 µL de una dilución 1 × 103 UFC/ml de Bacillus en cada punto, al mismo tiempo se colocó un control sin inóculo bacteriano. Las cajas Petri se dejaron en incubación a 28 °C ± 1 °C en una cámara de crecimiento. El crecimiento micelial de la colonia con respecto al punto del inóculo se midió a 48 h, 72 h y 96 h. El procedimiento se realizó en tres cajas Petri con tres inóculos por caja con la finalidad de tener nueve repeticiones para cada competencia. Este procedimiento también se llevó a cabo para la cepa de B. subtilis “tipo”. Los valores de crecimiento del micelio de las cinco cepas y la cepa de B. subtilis “tipo” se usaron para calcular el porcentaje de inhibición del crecimiento micelial calculado con la siguiente la fórmula: % I.C.M. = (C - T/C) × 100. Dónde: % I.C.M.= es el porcentaje de inhibición del crecimiento del micelio. C = es el crecimiento del micelio al punto del inoculo en la caja de Petri correspondiente al control sin inoculo bacteriano; y T = es el crecimiento del micelio al punto del inoculo en la caja de Petri correspondiente al tratamiento.
Análisis estadísticos
Para evaluar si las cepas presentaban diferencias significativas en la inhibición del crecimiento micelial de los hongos, los valores del porcentaje de inhibición del crecimiento radial se evaluaron a través de un análisis de varianza (ANOVA), usando para ello el programa estadístico Statical Package for the Social Sciences (SPSS) (versión 15.0). Posteriormente se aplicó una prueba múltiple de medias de Duncan para determinar el mayor porcentaje de inhibición.
Resultados
El primer objetivo de este estudio fue realizar el aislado de las cepas del orden Bacillales de lixiviados de lombricomposta. En este sentido, se caracterizaron cinco cepas de acuerdo a sus características morfológicas y bioquímicas todas pertenecientes al orden Bacillales. Dentro de la familia Bacillaceae se identificó a B. circulans, dos cepas de B. badius [aislado 1 (A1), aislado 2 (A2)] y B. licheniformis. También se aisló una cepa de la familia Paenibacillaceae de la cual se identificó como P. alvei (tabla 1).
Tabla 1 Pruebas bioquímicas, morfológicas, y fisiológicas de las cepas aisladas de lixiviados de lombricomposta.
| Especie | a | b | c | d | e | f |
|---|---|---|---|---|---|---|
| Swolle cell | + | - | - | - | - | |
| Espora | C | L | C | C | L | - |
| T° 55 C | + | - | - | - | + | + |
| pH 8 | + | + | + | + | + | - |
| pH 5 | + | + | + | - | + | + |
| Oxidasa | + | + | + | + | + | + |
| Anaerobiosis | - | - | - | - | - | - |
| Forma Colonial | R | P | PC | P | PC | RC |
| Rojo de Metilo | - | + | + | - | - | - |
| Nitrato | - | - | - | - | - | - |
| Glucosa | + | + | + | - | + | + |
| Ureasa | - | - | - | - | - | - |
| Gelatina | - | + | + | - | - | + |
| Arabinosa | + | + | + | - | + | + |
| Manitol | - | + | + | - | + | + |
| Catalasa | + | + | + | + | + | + |
| NaCl 6.5% | + | + | + | + | + | + |
| Citrato de Simmons | - | - | - | - | + | + |
| Diámetro ≥1 | - | - | + | - | - | - |
| V. P. | - | - | - | + | + | + |
| Almidón | + | + | + | + | + | + |
| Cepa | B1 | B2 | B3 | B4 | B5 | B. subtilis |
a) B. circulans; b) B. badius Al; c) B. badius A2; d) P. alvei; e) B. licheniformis; f ) B. subtilis; + Positivo; - Negativo; R: Rizoide; P: Plana; PC: Plana cremosa; RC: Rizoide Cremosa; C: Céntrica; L: Lateral; V.P.: Voges-Proskauer.
Fuente: Elaboración propia.
El segundo objetivo del presente trabajo fue evaluar el efecto de las bacterias aisladas del lixiviado sobre el crecimiento del micelio de cuatro hongos fitopatógenos. Los valores del porcentaje de inhibición del crecimiento del micelio se evaluaron a través de una ANOVA. Los resultados mostraron que a las 48 h de incubación existieron diferencias significativas (p < 0.05) en la inhibición del crecimiento del micelio (tabla 2). La bacteria B. badius Al y B. licheniformis mostraron los porcentajes de inhibición más elevados sobre F. oxysporum (tabla 2). Con respecto a P. capsici, las cepas B. licheniformis y P. alvei inhibieron en mayor proporción. Sin embargo, B. subtilis “tipo” no mostró ningún efecto de inhibición contra este hongo. P. alvei y B. badius A2 presentaron los valores de inhibición más elevados sobre Rhizopus sp., caso contrario, B. circulans se comportó igual que el control. Las demás bacterias presentaron porcentajes de inhibición del 20%. Las cepas B. badius A2 y B. subtilis “tipo” mostraron un porcentaje de inhibición del 49% sobre A. solani, mientras que B. circulans mostró una inhibición del 24% (tabla 2).
Tabla 2 Porcentaje de inhibición de seis bacterias del orden Bacillales sobre el creci miento micelial de F. oxysporum, P. capsici, A. solani y Rhizopus sp. después de un periodo de competencia de 48 h. Las diferentes letras en la columna indican diferencias significativas de p < 0.05.
| Cepas | Hongos fitopatógenos | |||
|---|---|---|---|---|
| F. oxysporum | P. capsici | Rhizopus sp. | A. solani | |
| B. circulans | 0.00 ± 4.35a | 20.31±10.04bc | 0.00 ± 0.00a | 24.44 ± 4.71b |
| B. badius Al | 19.78 ± 9.80b | 14.61± 9.99b | 20.74 ± 6.18b | 45.18 ± 2.94d |
| B. badius A2 | 0.00 ±12.58a | 25.38±11.92cd | 26.66 ± 7.45c | 49.63 ± 3.51e |
| P. alvei | 0.00 ± 8.01a | 33.86 ±14.92d | 31.11± 3.33d | 27.4 ± 4.00b |
| B. licheniformis | 23.73 ± 4.26b | 58.50 ± 11.10e | 20.00 ± 3.33b | 40.74 ± 5.21c |
| B. subtilis | 0.00 ± 4.79a | 0.00 ± 0.00a | 20.00 ± 3.33b | 49.62 ± 4.84e |
| Control | 0.00 ± 0.00a | 0.00 ± 0.00a | 0.00 ± 0.00a | 0.00 ± 0.00a |
Fuente: Elaboración propia.
A las 72 h de competencia también se observaron diferencias significativas (p < 0.05) en todos los tratamientos (tabla 3). Las cepas B. badius Al y B. licheniformis mostraron una inhibición de un 40% sobre F. oxysporum. Sin embargo, B. subtilis “tipo” solo inhibió un 20%. A este mismo tiempo B. licheniformis también mostró una inhibición del 64% sobre P. capsici, mientras B. subtilis “tipo” solo inhibió un 2%. El efecto inhibitorio sobre Rhizopus sp. se observó más efectivo por P. alvei al inhibir el 31% a diferencia de B. circulans y B. subtilis “tipo” que se comportan igual que el control. Las cepas de B. badius Al, B. badius A2, B. licheniformis y B. subtilis “tipo” mostraron un efecto inhibitorio muy similar de 30% a 40% sobre la cepa de A. solani. Sin embargo, el menor efecto se observó para la cepa P. alvei que presentó un valor de 10%.
Tabla 3 Porcentaje de inhibición de las bacterias del orden Bacillales sobre el crecimiento micelial de F. oxysporum, P. capsici, Rhizopus sp. y A. solani después de un periodo de competencia de 72 h. Las diferentes letras en la columna indican diferencias significativas de una p < 0.05.
| Cepas | Hongos fitopatógenos | |||
|---|---|---|---|---|
| F. oxysporum | P. capsici | Rhizopus sp. | A. solani | |
| B. circulans | 21.48 ± 2.94c | 15.55 ± 3.33b | 0.00 ± 0.00a | 19.47 ± 3.66b |
| B. badius Al | 40.00 ± 6.66d | 34.81 ± 6.47c | 19.25 ± 4.00c | 42.75 ± 5.91cd |
| B. badius A2 | 18.51 ± 6.47c | 35.55 ± 4.71c | 27.4 ± 7.77d | 44.28 ± 5.2cd |
| P. alvei | 20.74 ± 8.46c | 30.37 ± 9.49c | 31.11 ± 3.33d | 20.95 ± 4.87b |
| B. licheniformis | 42.96 ± 3.51d | 71.11 ± 6.66d | 18.51 ± 2.94c | 39.78 ± 6.71c |
| B. subtilis | 8.89 ± 3.33b | 20.00 ± 4.71b | 0.00 ± 0.00b | 47.30 ± 3.77d |
| Control | 0.00 ± 0.00a | 0.00 ± 0.00a | 0.00 ± 0.00a | 0.00 ± 0.00a |
Fuente: Elaboración propia.
Al evaluar la competencia de las bacterias a las 96 h también se observaron diferencias significativas (p < 0.05) entre los porcentajes de inhibición (tabla 4). B. badius Al y B. licheniformis mostraron los porcentajes de inhibición más elevados con valores arriba del 40%, mientras que la cepa de B. subtilis los valores más bajos de inhibición sobre F. oxysporum (tabla 4, figura 1), así mismo B. licheniformis inhibió en mayor proporción (70%) a P. capsici, sin embargo, la cepa B. circulans mostró el porcentaje de inhibición más bajo (tabla 4, figura 2). La cepa P. alvei presentó los valores de inhibición más elevados sobre Rhizopus sp., caso contrario a la cepa B. circulans y B. subtilis se comportaron igual que el control (tabla 4, figura 3). Las cepas B. badius A1 y A2, y B. subtilis mostraron un porcentaje de inhibición por arriba del 40% sobre la cepa de A. solani, mientras que B. circulans mostró una inhibición del 19% (tabla 4, figura 4).
Tabla 4 Porcentaje de inhibición de las bacterias del orden Bacillales sobre el crecimiento micelial de F. oxysporum, P. capsici, Rhizopus sp. y A. solani después de un periodo de competencia de 96 h. Las diferentes letras en la columna indican diferencias significativas de una p < 0.05.
| Cepas | Hongos fitopatógenos | |||
|---|---|---|---|---|
| F. oxysporum | P. capsici | Rhizopus sp. | A. solani | |
| B. circulans | 21.48 ± 2.94c | 15.55 ± 3.33b | 0.00 ± 0.00a | 19.47 ± 3.66b |
| B. badius Al | 40.00 ± 6.66d | 34.81 ± 6.47c | 19.25±4.00c | 42.75±5.91cd |
| B. badius A2 | 18.51 ± 6.47c | 35.55 ± 4.71c | 27.4 ± 7.77d | 44.28 ± 5.2cd |
| P. alvei | 20.74 ± 8.46c | 30.37 ± 9.49c | 31.11 ± 3.33d | 20.95 ± 4.87b |
| B. licheniformis | 42.96 ± 3.51d | 71.11 ± 6.66d | 18.51 ± 2.94c | 39.78±6.71c |
| B. subtilis | 8.89 ± 3.33b | 20.00 ± 4.71b | 0.00 ± 0.00b | 47.30 ± 3.77d |
| Control | 0.00 ± 0.00a | 0.00 ± 0.00a | 0.00 ± 0.00a | 0.00 ± 0.00a |
Fuente: Elaboración propia.

Fuente: Elaboración propia.
Figura 1 Efecto de las cepas del orden Bacillales en el crecimiento micelial de F. oxysporum a las 96 h de competencia. a) Control de F. oxysporum, b) B. licheniformis vs F. oxysporum, c) P. alvei vs F. oxysporum, d) B. badius A2 vs F. oxysporum, e) B. badius A1 vs F. oxysporum; f) B. circulans vs F. oxysporum y g) B. subtilis vs F. oxysporum.
Fuente: Elaboración propia.
Figura 2 Efecto de las cepas del orden Bacillales en el crecimiento micelial de P. capsici a las 96 h de competencia. a) Control de P. capsici, b) B. licheniformis vs P. capsici, c) P. alvei vs P. capsici, d) B. badius A2 vs P. capsici, e) B. badius A1 vs P. capsici, f) B. circulans vs P. capsici y g) B. subtilis vs P. capsici.

Fuente: Elaboración propia.
Figura 3 Efecto de las cepas del orden Bacillales en el crecimiento micelial de Rhizopus sp. a las 96 h de competencia. a) Control de Rhizopus sp. b) B. licheniformis vs Rhizopus sp., c) P. alvei vs Rhizopus sp., d) B. badius A2 vs Rhizopus sp., e) B. badius A1 vs Rhizopus sp., f) B. circulans vs Rhizopus sp. y g) B. subtilis vs Rhizopus sp

Fuente: Elaboración propia.
Figura 4 Efecto de las cepas del orden Bacillales en el crecimiento micelial so bre A. solani a las 96 h de competencia. a) Control de A. solani, b) B. licheniformis vs A. solani, c) P. alvei vs A. solani, d) B. badius A2 vs A. solani, e) B. badius A1 vs A. solani, f) B. circulans vs A. solani y g) B. subtilis vs A. solani.
Discusión
El control de enfermedades en plantas producidas por los hongos patógenos se realiza principalmente con pesticidas sintéticos. Sin embargo, se ha demostrado que un gran número de productores agrícolas en pequeña escala no tienen el acceso a este tipo de productos. Aunado a esto, el uso inadecuado y la sobreexplotación de estos productos ha generado problemas ecológicos y de salud. Esto ha ocasionado un gran desafío para buscar productos más amigables con el medioambiente. Es por ello que se estudia el proceso de lombricompostaje en el cual se ha descrito la presencia de una amplia cantidad de bacterias que ayudan a la degradación de la materia orgánica (Félix-Herrán et al., 2010). Uno de los grupos bacterianos que destacan en estos ambientes son las cepas del orden Bacillales las cuales se han reportado en el tracto digestivo de Eiseia foetida (Kim, Shin, Cha & Hur, 2004). Se ha descrito que estas bacterias secretan enzimas que no afectan a la lombriz y benefician la digestión y degradación de la materia orgánicas (Brito-Vega & Espinosa-Victoria, 2009). Un grupo importante de bacterias presentes en los lixiviados de lombricomposta es el del orden Bacillales el cual representa el 10% (Romero-Tepal et al., 2014). En nuestro estudio se aislaron 5 cepas del orden Bacillales, cuatro pertenecientes al género Bacillus. Se ha descrito que estas especies de bacterias son endobiontes dentro del tracto digestivo de E. foetida (Kim et al., 2004) y que tienen la capacidad de secreción de hormonas de crecimiento vegetal (Romero-Tepal et al., 2014), sustancias con capacidad de solubilización de fosfatos, producción de ácido indolacético, sideroforos y tienen la capacidad de realizar una inhibición del crecimiento de hongos (Tejera-Hernández et al., 2011). Además, la especie P. alvei (cepa B4) se ha descrito como degradadora de materia orgánica en procesos de compostaje (Silva et al., 2009). Se conoce ampliamente que las especies pertenecientes al género Bacillus son genéticamente muy heterogéneas, alcanzando diferencias fenotípicas intraespecie de un 30% (Calvo & Zuniga, 2010) y presentan variaciones morfológicas y bioquímicas en las cepas de una misma especie (Nakamura, Roberts & Cohan, 1999), lo que hace que al identificar estas cepas presenten diferencias como las observadas en este estudio. En este sentido, se describió una variación intraespecie entre las cepas B. badius A1 y B. Badius A2, debido a que presentaron diferencias morfológicas coloniales y microscópicas al momento de la identificación (tabla 1). Las bacterias del orden Bacillales presentes en lixiviados de lombricomposta provienen de la materia prima a lombricompostaje, sin embargo, existe una sucesión bacteriana al pasar por el tracto digestivo de la lombriz en la que las propiedades de las bacterias se mejoran y algunos casos se encuentran nuevas especies, además de que la competencia de microrganismos en el proceso beneficia a las bacterias para generar un efecto sobre otros organismos (De La Mora, Vazquez & Galvan, 2016).
Al evaluar la competencia de las bacterias contra las cepas de hongos fitopatógenos se observaron diferencias significativas entre los porcentajes de inhibición (tabla 4). El uso de organismos que funcionan como biocontroladores de enfermedades causadas por hongos se ha estudiado ampliamente, sin embargo, hay pocos estudios relacionados con bacterias aisladas de lombricomposta. En este estudio se observó que B. circulans presenta valores bajos de inhibición de crecimiento para todos los tiempos evaluados. Estos resultados son contradictorios a los encontrados por Mehta,Chauhan, Mahajan & Shirkot (2010) en donde dicha bacteria inhibe el crecimiento micelial de F. oxysporum y R. solani (50%) y Sclerotinia scleotiorum (55%). Esta especie se ha relacionado con la producción de sideroforos y la solubilización de fosfatos (Mehta et al., 2010) y se ha comprobado que también es una especie secretora de quitinasa (Simonen & Palva, 1993); sin embargo, en el estudio la inhibición fue baja. Esto podría deberse al tiempo de adaptación y crecimiento de la colonia bacteriana en el medio, ya que presenta una adaptación completa hasta las 48 h a diferencia de las otras cepas que es a las 24 h. También se observó que el crecimiento micelial se mantiene constante sin una inhibición, este comportamiento se presentó principalmente en la competencia con Rhizopus sp. en la que se observa que a las 48 h de competencia Rhizopus creció hasta el filo de la caja Petri sin importar la presencia de la cepa.
La cepa B. badius Al mostró diferencias significativas en la inhibición de F. oxysporum con respecto a B. badius A2, sin embargo, para P. capsici, A. alternata y Rhizopus sp. no mostró ninguna diferencia significativa entre ambas cepas (tabla 4). En otros estudios se ha observado una inhibición del crecimiento micelial de Fusarium sp., Helmithosporium sp., Aspergillus sp. (Raval & Desai, 2015), Erwinia carotovora y Pseudomonas sp. (Kuta, Nimzing & Orka'a, 2009). La diferencia intraespecífica además de reflejarse en algunas bioquímicas se ve en la capacidad para inhibir organismos ya que no presenta la misma respuesta teniendo una variación en compuestos que secretan frente a competidores (tabla 4).
P. alvei presentó los valores de inhibición más altos para Rhizopus sp. inhibiendo en un 31% a las 96 h. Pero presentó valores bajos cuando se comparó con los otros hongos fitopatógenos, cabe resaltar que para las 48 h el porcentaje de inhibición en F. oxysporum es igual al control, en el que se observa una respuesta por parte del fitopatógenos a la presencia de P. alvei realizando un crecimiento de su micelio con la finalidad de ganar espacio disponible de nutrientes. Estos resultados son diferentes a los mostrados por esta cepa contra Verticillium dahlie. Contra este hongo se ha observado que esta cepa tiene la capacidad de secretar quitinasas las cuales reducen hasta un 70% el crecimiento micelial (Tjamos, Tsitsigiannis, Tjamos, Antoniou & Katinakis, 2004). Lo cual se infiere como mecanismo de inhibición para Rhizopus sp. en donde las quitinasas pueden degradar la pared del micelio impidiendo su desarrollo y crecimiento, sin embargo, la secreción no se presenta en abundancia y no se genera la misma respuesta al estar presente otros hongos.
B. licheniformis presentó los valores más altos de inhibición sobre F. oxysporum y P. capsici a las 96 h de competencia (tabla 4). Se ha reportado que esta bacteria tiene la capacidad de secreción de enzimas quitinolíticas, como quitinasas que hidrolizan el enlace glucosídico β1-4 y degradan polímeros en oligómeros y monómeros en N-acetil-glucosamina (Sastoque-cala, Mercado-Reyes, Martínes-Salgado, Quevedo-Hidalgo & Pedroza-Rodríguez, 2007; Wang et al., 2014) componentes principales en la pared del micelio de F. oxysporum y A. alternata (Bar-Nun, L’Hyvernay, Donèche & Mayer, 2007; Fesel & Zuccaro, 2016; Schoffelmeer, Klis, Sietsma & Cornelissen, 1999), además esta bacteria tiene la capacidad de la secretar glucanasas, las cuales degradan los enlaces β1-3 glucanos y β1-6 glucanos (Corrales, Sanchez, Cuervo, Joya & Marquez, 2012; Zakaria, 2012), los cuales son componentes principales en la estructura del micelio de P. capsici (BartnickiGarcia, 1966). Otros estudios han mostrado que además de glucanasas esta cepa puede secretar diversas proteasas, liasas e hidrolasas que benefician la inhibición del crecimiento micelial de diversos hongos fitopatógenos (Tang-Bing, Hai-yun & Li-Xian, 2012), por lo que es un posible mecanismo usado por la bacteria para causar un efecto sobre el crecimiento del micelio de los hongos. También se ha reportado la presencia de metabolitos secundarios que funcionan como inhibidores tales como la iturina A y surfactina que en presencia de un organismo son secretados para causar un daño y competir en la disponibilidad de alimentos (Ragazzo-Sánchez, Robles-Cabrera, Lomeli-Gonzalez, Luna-Solano & Calderón-Santoyo, 2011). Los resultados mostrados en este estudio se relacionan con los reportados por Lim & Kim (2010) donde especifica que esta cepa tiene la capacidad de reducir la incidencia de Phytophthora (80%), Fusarium sp. (70%) (Corrales et al., 2012) y Rhizopus sp. (42%) (Chávez-Díaz, AngoaPérez, López-Díaz, Velázquez-del Valle & HernándezLauzardo, 2014). Estos resultados muestran que esta bacteria presenta una capacidad de inhibición para una variedad amplia de cepas de hongos, aunque se desconoce todos los compuestos usados para realizar la inhibición en presencia de los diferentes hongos.
Se ha documentado que la especie bacteriana B. subtilis tiene características de inhibición para diversos hongos (Nagórska, Bikowski & Obuchowski, 2007) por lo que fue usada como control. Sin embargo, la cepa “tipo” utilizada en este estudio presentó los valores de inhibición más bajos en todos los tiempos, lo cual nos hace inferir que el método de preservación pudiera afectar a la capacidad de respuesta frente a organismos competidores. Esto se ha especulado entre algunos microbiólogos debido a que se pierde cierta capacidad al congelarse (Morales-García et al., 2010). Algunos métodos de preservación como la congelación no son viables para la recuperación de las cepas después de un periodo largo (Parra, Pérez, Bernal, Suárez & Montoya, 2006). No obstante, no se descarta la capacidad de esta especie de inhibir el crecimiento de los hongos ya que se observa una pequeña capacidad de disminución del crecimiento sobre F. oxysporum y P. capsici, y en mayor medida sobre A. solani. Cabe resaltar que lo observado sobre el hongo del género Rhizopus sp. no es el comportamiento real, debido a que después de finalizar las 96 h de competencia se observó que en el momento de que el estolón o una hifa aérea alcanzara a tocar la cepa esta crecía sobre el micelio del hongo y en un lapso de 120 h se observaba la completa disminución del micelio de Rhizopus sp. Este comportamiento fue predominante en la cepa B. licheniformis y B. badius A2, estos datos no fueron reportados debido a que se desconocía este comportamiento por lo que se propone realizar estudios posteriores (figura 3).
De manera general se reporta la presencia de cepas del orden Bacillales dentro de los lixiviados de lombricomposta que contribuyen con la capacidad de inhibir hongos causantes de enfermedades en plantas y se destaca a la cepa de B. licheniformis (B5) y B. badius (B2) como potenciales biocontroladoras de hongos en cultivos vegetales, además de la aplicación de lixiviados de lombricomposta como biofertilizantes siempre que se realice el proceso adecuado de lombricomposteo.
Conclusión
Las cepas del orden Bacillales se encuentran presentes en lixiviados de lombricomposta por lo que se destaca su capacidad para servir como beneficio para el suelo. Las cepas presentaron capacidad de inhibición sobre los hongos del género Alternaria, Fusarium, Rhizopus y Phytophthora observando la mayor capacidad en la cepa B5 identificada como B. licheniformis sobre Phytophthora y la cepa B2 que se identificó como B. badius ejerció un efecto casi igual para todos los hongos por lo que el uso de las cepas del orden Bacillales como biocontroladores de diversos hongos patógenos puede funcionar de manera efectiva y amigable para el ambiente.










nueva página del texto (beta)


